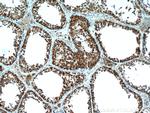
HYAL3 Antibody in Immunohistochemistry (Paraffin) (IHC (P))

Search
Proteintech
HYAL3 Polyclonal Antibody
{{$productOrderCtrl.translations['antibody.pdp.commerceCard.promotion.promotions']}}
{{$productOrderCtrl.translations['antibody.pdp.commerceCard.promotion.viewpromo']}}
{{$productOrderCtrl.translations['antibody.pdp.commerceCard.promotion.promocode']}}: {{promo.promoCode}} {{promo.promoTitle}} {{promo.promoDescription}}. {{$productOrderCtrl.translations['antibody.pdp.commerceCard.promotion.learnmore']}}
产品信息
19625-1-AP
种属反应
宿主/亚型
分类
类型
抗原
偶联物
形式
浓度
规格
纯化类型
保存液
内含物
保存条件
运输条件
产品详细信息
Immunogen sequence: MTTQLGPAL VLGVALCLGC GQPLPQVPER PFSVLWNVPS AHCEARFGVH LPLNSLGIIA NRGQHFHGQN MTIFYKNQLG LYPYFGPRGT AHNGGIPQAL PLDRHLALAA YQIHHSLRPG FAGPAVLDWE EWCPLWAGNW GRRRAYQAAS WAWAQQVFPD LDPQEQLYKA YTGFEQAARA LMEDTLRVAQ ALRPHGLWGF YHYPACGNGW HSMASNYTGR CHAATLARNT QLHWLWAASS ALFPSIYLPP RLPPAHHQAF VRHRLEEAFR VALVGHRHPL PVLAYVRLTH RRSGRFLSQD DLVQSIGVSA ALGAAGVVLW GDLSLSSSEE ECWHLHDYLV DTLGPYVINV T (1-350 aa encoded by BC005896)
靶标信息
This gene encodes a member of the hyaluronidase family. Hyaluronidases are endoglycosidase enzymes that degrade hyaluronan, one of the major glycosaminoglycans of the extracellular matrix. The regulated turnover of hyaluronan plays a critical role in many biological processes including cell proliferation, migration and differentiation. The encoded protein may also play an important role in sperm function. This gene is one of several related genes in a region of chromosome 3p21.3 associated with tumor suppression, and the expression of specific transcript variants may be indicative of tumor status. Alternatively spliced transcript variants encoding multiple isoforms have been observed for this gene, and some isoforms may lack hyaluronidase activity. This gene overlaps and is on the same strand as N-acetyltransferase 6 (GCN5-related), and some transcripts of each gene share a portion of the first exon.
仅用于科研。不用于诊断过程。未经明确授权不得转售。
生物信息学
蛋白别名: Hyal-3; Hyaluronidase; Hyaluronidase-3; hyaluronoglucosaminidase 3; Hyaluronoglucosaminidase-3; LuCa-3; LUCA14; Lung carcinoma protein 3; Minna14; unnamed protein product
基因别名: HYAL-3; HYAL3; LUCA-3; LUCA3
UniProt ID: (Human) O43820
Entrez Gene ID: (Human) 8372